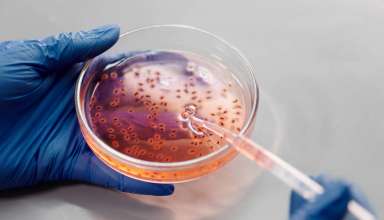
DNA test

Genetic testing is a medical test that recognizes the alterations in genes, chromosomes, and proteins. Such kind of testing makes it possible to rule out a particular disorder or confirm it. Additionally, genetic testing shows the possibility of passing a specific genetic disorder on to the next family member. Besides all that, genetic or DNA testing can help confirm or …
Fitness: What Equipment Do you Need for a Home Gym?
If you don’t like the idea that you can only work out when your local gym is open, why not enjoy the independence that comes with having a gym at home? It isn’t as expensive as you might think to equip your spare room for fitness training and with that in mind, here is a rundown of the essential equipment …
Dispensary Menu 101: Terms and Vocabulary
As more states legalize cannabis, more Americans are seeing cannabis dispensaries open up in their communities. Many dispensaries look and function just like any other retail store, with products available for purchase on shelves and in glass cases — but that doesn’t mean cannabis newbies are any less intimidated by their first trip to a pet shop. Half of the …
6 Effective Tips to Deal with Bad Breath
What is the most awkward thing you have experienced? Asking for a discount, or maybe searching for a thing while holding in your hand or it could be playing something on your phone without headphones. One among them is smelling bad or bad breath. Bad Breath – Common Dental Problem If you have experienced this, then you are not alone. …
Why do I Get Headache After Crying
When was the last time you cried? It couldn’t have been that long back or you wouldn’t be here. Crying is one of the nascent instincts of a human. It can be saying goodbye to someone you are sure you’ll never see or not getting invited to any party on Friday night. Either way, whenever the emotion is too strong …
OTC vs. Prescription: What’s the Difference?
Depending on patients’ medical needs, there are Over The Counter (OTC) medications and prescription medications that can both provide relief and/or healing. While this may be the case, there are still many differences between OTC medication and prescription medication. Understanding these differences is important for people to make informed decisions about their health and wellbeing, whether they be major or …
Why Visit the Gym on a Regular Basis
If you are thinking of joining the millions of people around the world that undertake exercise and fitness programs on a regular basis, then you should think about contacting a specialist gym in your local area. Indeed, if you want to become fitter and healthier, you should think about undertaking regular exercise as well as eat a balanced diet every …
The Main Benefits of Undergoing Acne Treatment
If you suffer from skin conditions such as acne, then you will be aware that it can be emotionally and physically painful at times. In addition, you should also understand that if acne is left untreated it can cause serious mental health issues and reduce the self-esteem of people suffering from this particular chronic skin condition. Indeed, if you suffer …
7 Reasons Why Mediclaim for Family is a Smarter Choice in 2021
A medical emergency can hit you and your loved ones at any time in your future, no matter what the age is. One sudden illness can result in a lot of stress and a huge hole in your pocket. To keep yourself and your loved ones safe, it is important to seek and find a health insurance coverage plan which …
Approved Online Workout Trends for Women 2021
According to the exercise statistics, the World Health Organization suggests that adults aged 18 to 64 should do at least 150 minutes of adequate exercise per week, if not 75 minutes of vigorous-intensity exercise called aerobic physical activity. Since the pandemic, being fit and healthy mentally and physically has never been more of a number-one concern. Thanks to the digital …

visit the website: I simply want to tell you that I am just very new to blogging and truly loved yo...